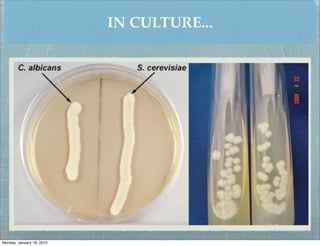
IN CULTURE...




Monday, January 16, 2012

The document discusses various opportunistic mycoses caused by yeasts and molds. It describes the classification of organisms that cause opportunistic mycoses like Candida, Aspergillus, and Zygomycetes. It provides details on diseases caused, host factors, clinical manifestations, laboratory diagnosis and treatment of common fungal infections including candidiasis, aspergillosis, and mucormycosis.